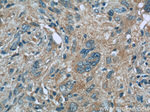
MLF1IP Antibody in Immunohistochemistry (Paraffin) (IHC (P))

Search
Proteintech
MLF1IP Polyclonal Antibody
{{$productOrderCtrl.translations['antibody.pdp.commerceCard.promotion.promotions']}}
{{$productOrderCtrl.translations['antibody.pdp.commerceCard.promotion.viewpromo']}}
{{$productOrderCtrl.translations['antibody.pdp.commerceCard.promotion.promocode']}}: {{promo.promoCode}} {{promo.promoTitle}} {{promo.promoDescription}}. {{$productOrderCtrl.translations['antibody.pdp.commerceCard.promotion.learnmore']}}
产品信息
13186-1-AP
种属反应
宿主/亚型
分类
类型
抗原
偶联物
形式
浓度
规格
纯化类型
保存液
内含物
保存条件
运输条件
产品详细信息
Immunogen sequence: MKTSDIKEL NIVLPEFEKT HLEHQQRIES KVCKAAIATF YVNVKEQFIK MLKESQMLTN LKRKNAKMIS DIEKKRQRMI EVQDELLRLE PQLKQLQTKY DELKERKSSL RNAAYFLSNL KQLYQDYSDV QAQEPNVKET YDSSSLPALL FKARTLLGAE SHLRNINHQL EKLLDQG (243-418 aa encoded by BC031520 )
靶标信息
The function of this protein remains unknown.
仅用于科研。不用于诊断过程。未经明确授权不得转售。
生物信息学
蛋白别名: ATPase protein HES; CENP-50; CENP-U; Centromere protein of 50 kDa; Centromere protein U; Interphase centromere complex protein 24; KLIP1; KSHV latent nuclear antigen interacting protein 1; KSHV latent nuclear antigen-interacting protein 1; MLF1 interacting protein; MLF1-interacting protein; myeloid leukemia factor 1 interacting protein; nuclear protein; nuclear transcriptional repressor; Polo-box-interacting protein 1; unnamed protein product
基因别名: 1700029A22Rik; CENP50; CENPU; CENPU50; ICEN24; KLIP1; MLF1IP; PBIP1
UniProt ID: (Human) Q71F23, (Rat) Q4V8G7, (Mouse) Q8C4M7
Entrez Gene ID: (Human) 79682, (Rat) 306464, (Mouse) 71876